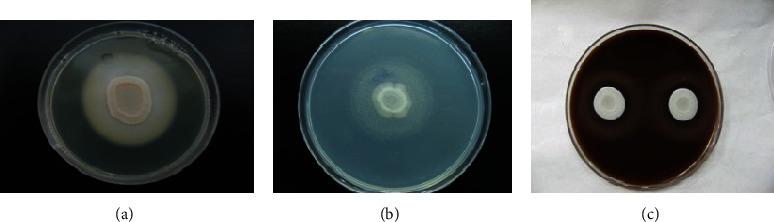
https://cdn.ncbi.nlm.nih.gov/pmc/blobs/505b/8175137/2816518fe899/BMRI2021-9982744.001.jpg

从糖尿病患者口腔中分离出的 种的潜在致病性。
Potential Pathogenicity of Species Isolated from Oral Cavity of Patients with Diabetes Mellitus.
机构信息
Department of Parasitology and Mycology, School of Medicine, Shiraz University of Medical Sciences, Shiraz, Iran.
Department of Radiology, School of Medicine, Medical Imaging Research Center, Shiraz University of Medicine Sciences, Shiraz, Iran.
出版信息
Biomed Res Int. 2021 May 26;2021:9982744. doi: 10.1155/2021/9982744. eCollection 2021.
INTRODUCTION
In the recent decade, the increased immunocompromised population such as diabetic patients makes a high incidence of invasive infections. Diabetes mellitus is the most common endocrine metabolic disorder, and diabetic patients are more susceptible to oral candidiasis infection. Candidiasis is an opportunistic fungal infection caused by many species of . Secretion of exoenzymes plays an important role in the virulence and pathogenesis of species. The aim of this study was to evaluate the potential role of phospholipase, esterase, and hemolytic activity of species isolated from oral cavity lesions of diabetic patients.
METHODS
A total of 108 species including 75 and 33 non- species were recovered from the oral cavity of diabetic patients included in our study. Egg yolk agar, Tween 80 opacity medium, and blood agar plate assays were used for determining phospholipase, esterase, and hemolytic activities, respectively.
RESULTS
species had the most exoenzyme activity in comparison to non isolates. isolates showed 97.3%, 100%, and 77.3% phospholipase, hemolysin, and esterase activities, respectively. The difference between and non- was significant in phospholipase ( < 0.001) and hemolytic activity ( = 0.027), but not significant in esterase activity ( = 0.076).
CONCLUSION
This study showed that most of the isolates had different enzymatic patterns, and isolates had the most exoenzyme activity. So due to the potential effects of these enzymes in pathogenesis and virulence effects of species, we can conclude that the severity of extracellular enzymes may play a role in the severity of signs and symptoms of oral cavity infections in diabetic patients.
简介
在最近十年中,由于糖尿病患者等免疫功能低下人群的增加,侵袭性感染的发病率较高。糖尿病是最常见的内分泌代谢紊乱,糖尿病患者更容易发生口腔念珠菌感染。念珠菌病是一种由多种引起的机会性真菌感染。外酶的分泌在种的毒力和发病机制中起重要作用。本研究旨在评估从糖尿病患者口腔病变中分离出的种的磷脂酶、酯酶和溶血活性的潜在作用。
方法
从纳入本研究的糖尿病患者口腔中回收了 108 株种,包括 75 株和 33 株非种。卵黄琼脂、吐温 80 不透明度培养基和血琼脂平板测定法分别用于确定磷脂酶、酯酶和溶血活性。
结果
与非种相比,种具有最强的外酶活性。种的磷脂酶、溶血素和酯酶活性分别为 97.3%、100%和 77.3%。种与非种之间在磷脂酶(<0.001)和溶血活性(=0.027)方面存在显著差异,但在酯酶活性(=0.076)方面无显著差异。
结论
本研究表明,大多数分离株具有不同的酶谱,种具有最强的外酶活性。因此,由于这些酶在种的发病机制和毒力作用中的潜在影响,我们可以得出结论,细胞外酶的严重程度可能在糖尿病患者口腔念珠菌感染的症状和体征的严重程度中起作用。